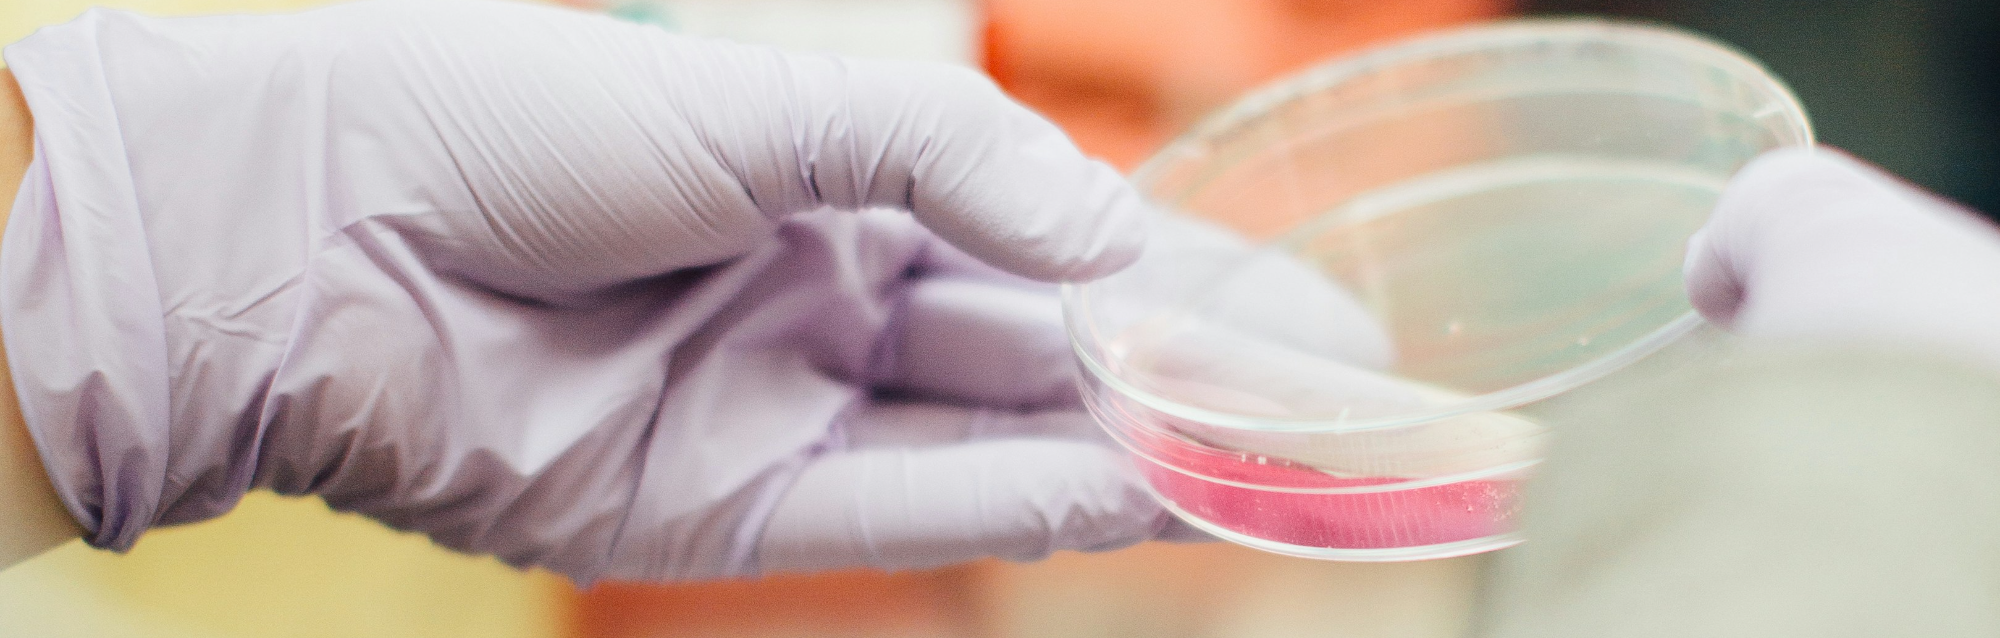

티스토리 뷰
요로결석 정의
요로결석은 요로계통 내에서 형성된 작은 결석으로, 주로 신장, 요관, 방광 등에서 발생할 수 있습니다. 이러한 결석은 요로를 통과하면서 통증을 유발할 수 있습니다. 주요 요로결석의 종류로는 신장 결석, 요관 결석, 방광 결석이 있습니다.
1. 신장 결석 : 신장 내에서 형성된 결석으로, 주로 요로 결석의 일부를 형성합니다. 크기와 위치에 따라 신장 결석은 통증을 유발할 수 있으며, 때로는 신장콩팥염과 같은 신장 문제를 유발할 수 있습니다.
2. 요관 결석 : 요관 내에서 형성된 결석으로, 주로 신장에서 방광으로 소변을 이동시키는 요로로 통과할 때 통증을 유발할 수 있습니다.
3. 방광 결석 : 방광 내에서 형성된 결석으로, 소변을 저장하는 기관으로서 결석이 형성될 수 있습니다. 큰 방광 결석은 소변 흐름을 차단할 수 있으며, 이로 인해 소변이 무엇보다도 방광을 통해 흐르지 않고 역류할 수 있습니다.
요로결석은 다양한 원인에 의해 발생할 수 있으며, 일반적으로 과다한 무기질 치료물질 또는 소변의 농축이 높은 경우 결석 형성 위험이 증가할 수 있습니다. 통증, 혈뇨, 소변 빈도 증가, 소변의 변화 등의 증상을 유발할 수 있으며, 치료는 결석의 크기와 위치에 따라 달라질 수 있습니다.
요로결석 원인
요로결석은 다양한 원인에 의해 발생할 수 있습니다.
1. 물질 농축 : 소변이 충분히 농축되거나 적절한 수분을 섭취하지 않을 경우 요로결석의 위험이 증가할 수 있습니다. 물질이 과도하게 농축되면 소변 내에서 결정화되어 결석을 형성할 가능성이 높아집니다.
2. 과다한 무기질 : 소변 내에 존재하는 과다한 무기질이 결석 형성에 기여할 수 있습니다. 이러한 무기질에는 칼슘, 인산염, 요소, 인산염 등이 포함될 수 있습니다.
3. 유전적 요인 : 가족력이 있는 경우 요로결석 발생 위험이 높아질 수 있습니다. 유전적 요인은 개인의 요로계통 내 무기질 대사와 관련된 유전적 변이로 인해 발생할 수 있습니다.
4. 식습관 : 고단백 식사, 고 나트륨 식사, 과다한 인산염 또는 옥산산을 함유하는 식품을 섭취할 경우 요로결석의 발생 위험이 증가할 수 있습니다.
5. 기타 요인 : 요로계통에 염증이나 감염이 있는 경우, 소변의 pH가 변화하는 경우, 요로계통에서 유석성 물질의 과도한 분비가 있는 경우 등의 상황이 요로결석의 발생에 영향을 줄 수 있습니다.
이러한 요인들은 개별적으로 또는 상호작용하여 요로결석을 유발할 수 있으며, 이러한 위험 요인을 감소시키는 것이 중요합니다. 충분한 수분 섭취, 건강한 식습관, 적절한 의학적 관리 등은 요로결석의 발생을 예방하고 위험을 줄이는 데 도움이 될 수 있습니다.
요로결석 종류
요로결석은 그 구성물에 따라 여러 종류로 나뉠 수 있습니다. 각각의 종류는 그 구조와 화학적 특성에 따라 다양한 원인과 증상을 가질 수 있습니다.
1. 칼슘 결석 : 칼슘 성분이 주로 구성하는 결석으로, 가장 흔한 종류 중 하나입니다. 칼슘 옥살산과 같은 칼슘화된 물질이 요로계통에서 축적되어 결석을 형성할 수 있습니다.
2. 요소 결석 : 요소 성분이 주로 구성하는 결석으로, 우리 몸이 요소를 다량으로 흡수하거나 신장이 요소를 충분히 배출하지 못할 경우 발생할 수 있습니다.
3. 요산결석 : 요산과 관련된 성분이 주로 구성하는 결석으로, 과다한 요산의 생성이나 분비로 인해 형성될 수 있습니다. 요산은 고단백 식품 섭취, 기타 요로계통 질환 등과 관련이 있습니다.
4. 인산염 결석 : 인산염과 같은 인성분이 주로 구성하는 결석으로, 과다한 인산의 섭취나 신장의 인 배출 기능이 저하되면 형성될 수 있습니다.
5. 혼합형 결석 : 두 종류 이상의 구성물을 가진 결석으로, 주로 다양한 물질이 요로계통에서 혼합하여 축적되어 형성됩니다.
요로결석의 종류는 환자의 건강 상태, 식습관, 유전적 요인 등에 따라 달라질 수 있으며, 종류에 따라 치료 및 예방 방법이 달라질 수 있습니다. 따라서 정확한 종류의 결석을 확인하고 해당하는 적절한 치료 방법을 전문의의 상담을 통해 고려하는 것이 중요합니다.
요로결석 초기 증상
1. 급성 통증 : 가장 흔한 초기 증상 중 하나는 급격한 통증입니다. 요로결석이 발생한 부위나 이동한 경로에 따라 통증의 위치와 강도가 달라질 수 있습니다. 통증은 종종 예기치 못한 때에 시작되며, 심하면 심지어 일상생활을 방해할 수 있습니다.
2. 혈뇨 : 요로결석이 발생하면 소변 내에 혈액이 혼합될 수 있습니다. 혈뇨는 종종 빨간색이나 갈색을 띠며, 소변의 색상이 비정상적으로 변할 수 있습니다.
3. 소변 변화 : 요로결석이 발생하면 소변의 색상, 투명도, 냄새 등이 변할 수 있습니다. 소변이 탁하거나 부적절한 냄새가 날 수 있으며, 때로는 소변의 양이 감소하거나 빈도가 증가할 수도 있습니다.
4. 복통 또는 요통 : 요로결석이 방광 또는 요관을 통과할 때 발생하는 혼란스럽고 통증을 동반할 수 있습니다. 통증은 종종 하복부나 한쪽 허벅지, 허리 등에서 느껴지며, 때로는 통증이 움직이는 느낌을 주기도 합니다.
5. 구토와 복부 불편 : 요로결석이 신장부터 방광으로 이동하는 동안 복부 또는 요관에 압력을 가해 복부 불편감이나 구토가 발생할 수 있습니다.
이러한 초기 증상은 요로결석의 위치, 크기, 형태 등에 따라 다를 수 있으며, 각 개인의 상황에 따라 다양할 수 있습니다. 만약 이러한 증상을 경험하고 있다면, 즉시 의료 전문가의 진단과 치료를 받는 것이 중요합니다.
'질병 예방' 카테고리의 다른 글
| 거식증 정의, 원인, 초기 증상, 예방 방법 (0) | 2024.05.11 |
|---|---|
| C형 간염 정의, 원인, 초기 증상, 예방 방법 (0) | 2024.05.10 |
| 방광암 정의, 원인, 종류, 초기 증상 (0) | 2024.05.08 |
| 알츠하이머 정의, 초기 증상, 원인, 예방 습관 (1) | 2024.05.06 |
| 동맥색전증 정의, 초기 증상, 원인, 음식 추천 (0) | 2024.05.05 |